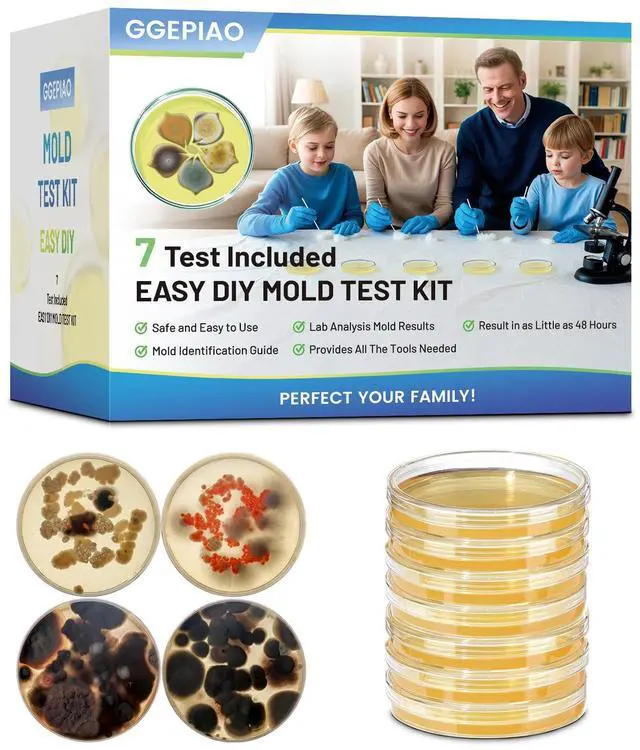
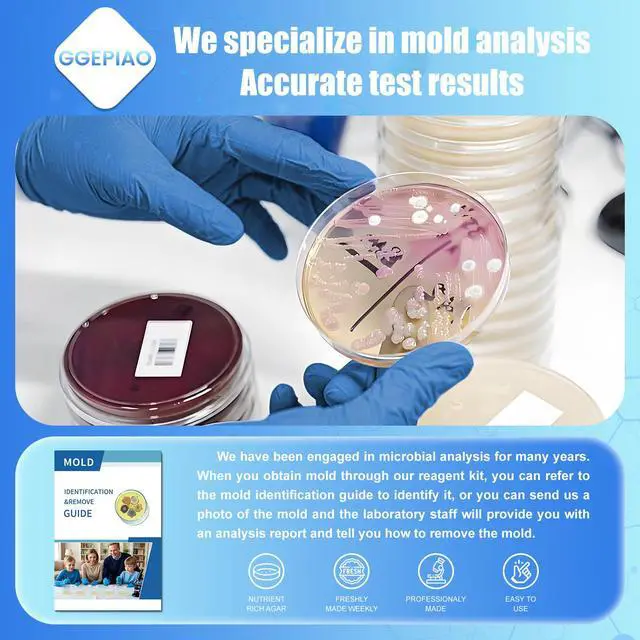
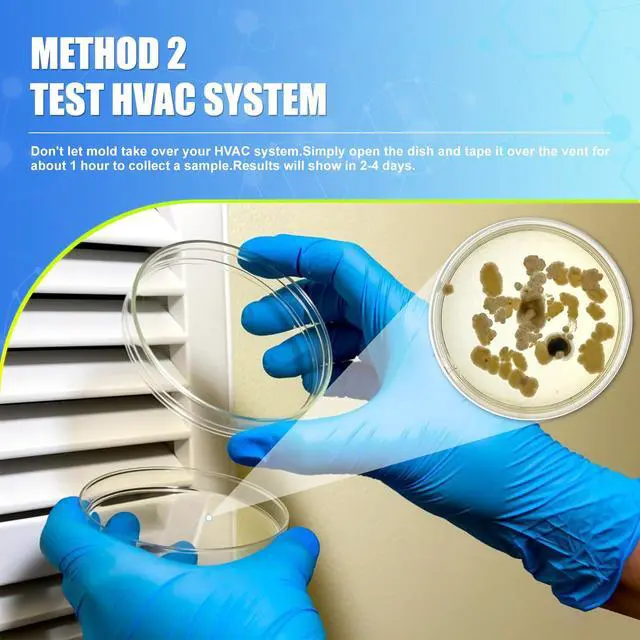
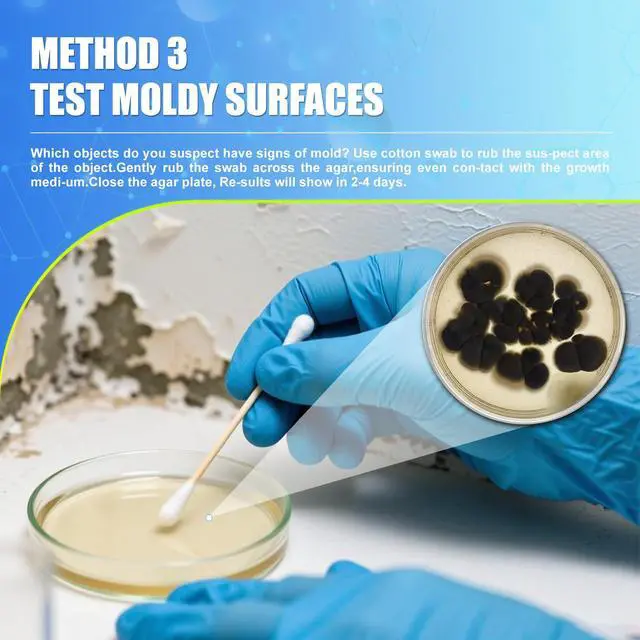

Your Browsing History

Any questions? Our AI beta will help you find out quickly.
Test on different parts of the home or office, such as Bathroom Corners, Under Kitchen Sink, Window Sill Gaps, Basement Walls, Washing Machine Rubber Gasket, Carpet Edges, Plant Saucers, Refrigerator Door Seal,Book Storage Boxes, Shoe Cabinet Interior, Ceiling Corners,Cloth Storage Bins, Back of Wooden Furniture, Damp Laundry Baskets